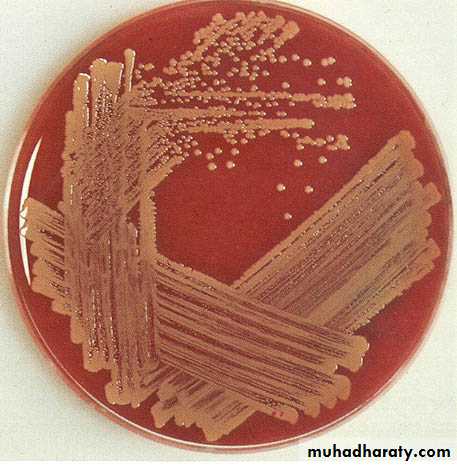

الدكتور
سعد يونس سليمانكلية طب نينوى
Adeno-Tonsillitis
ADENOID
The Nasopharyngeal Tonsil, commonly called "Adenoids",Position…
Composition.
It differs from palatine tonsil, How?
Adenoid tissue present at birth, shows physiological enlargement up to the age of six years, and then tends to atrophy at puberty and almost completely disappeared by the age of 20.
Situated at the junction of the roof and posterior wall of the nasopharynx
Composed of vertical ridges of lymphoid tissue separated by deep clefts and covered by ciliated columnar epitheliumHave no crypts and no capsule
Acute Adenoiditis
It is acute inflammation of the adenoid tissue.It may occur alone or in association with rhinitis or tonsillitis.
It produces pain behind the nose, postnasal discharge, nasal block and feeding difficulties in babies.
Treatment is usually medical.
Adenoid Enlargement (Adenoid Hypertrophy)
INCIDENCE:Age: Children.
AETIOLOGY:
1-Physiological hypertrophy. Occurs at the age of 3 - 8 years and produced from relative disproportion in size between the adenoids and the cavity of the nasopharynx.
2-Pathological hypertrophy. Due to recurrent upper respiratory infections.
SYMPTOMS:
1- Bilateral nasal obstruction =>* Mouth breathing.
* Speech hypo-nasality.
* Difficult suckling in infants.
* Snoring and obstructive sleep apnea.
2-Bilateral nasal discharge =>
* Mucoid or muco-purulent => due to mechanical obstruction of the choanae.* Excoriation of the nasal vestibule and upper lip.
* Post-nasal discharge=> nocturnal cough, laryngismus stridulus and gastro-intestinal disturbances as loss of appetite and morning vomiting.
SIGNS:
1- Posterior rhinoscopy => shows the adenoids, but is difficult.2- Endoscopic examination => the best.
INVESTIGATION:
Lateral plain x-ray of the nasopharynx: A soft tissue shadow narrowing the airway => diagnostic.
• COMPLICATIONS:
• 1- Obstructive sleep apnea:defined as a cessation of ventilation despite effort for 10 seconds in older children, or 6 seconds in younger infants. This may affect the patient in the following way:• a) During sleep; restless sleep (due to fragmentation of sleep by frequent arousal) night mares and nocturnal enuresis.
• b) During day time =>
• morning headache
• impaired concentration
• excessive daytime sleepiness
• (due to fragmentation of sleep)
• 2- Descending infections:
• Ear: Recurrent acute otitis media and secretory otitis media• Respiratory: Recurrent rhinitis, sinusitis, pharyngitis, laryngitis and bronchitis
• 3- Adenoids facies: Due to under-development of the middle 1/3 of the face
• a) Nose: Pinched nostril's• b) Mouth: Open mouth, short upper lip, protroding upper incisors, high arched palate and receding mandible
• c) Face: Idiot expressionless look.
TREATMENT:
Adenoidectomy operation => when adenoids is symptomatic or complicated.Adenoidectomy is indicated in:
• Upper airway obstruction causing sleep apnoea.
• Chronic nasopharyngitis refractory to medical treatment.
• Chronic or recurrent middle ear infection.
• Secretory otitis media.
• Chronic sinusitis.
DEFINITION:
Acute inflammation of the palatine tonsils.INCIDENCE:
Age: Any, but much more common in children.
Causative organisms:
1- Viral.
2- Streptococci (Group A Beta-hemolytic).
3- Staphylococci.
4- Haemophilus influenzae.
5- Pneumococci .
6- Anaerobes.
Mode of transmission: Droplet infection.
Acute Tonsillitis
Symptoms
General symptoms:Rapid onset of fever ( up to 40 degree)
Headache
Anorexia
Malaise.
There is often abdominal pain due to a mesenteric adenitis.
Pharyngeal symptoms:
a) Rapid onset of dysphagia and odynophagia with severe sore throat and referred otalgia
b) Bad mouth odour (halitosis).
c) voice changes
Signs
General signs: High fever and flushed face. Febrile convulsions may occur in children.Pharyngeal signs:
a) Acute parenchymatous tonsillitis: Marked hyperaemia and enlargement of the tonsils
b) Acute follicular tonsillitis: The crypts are full of purulent exudates. The surface of the tonsil has yellowish spots- characteristic spotted appearance
c) Acute membranous tonsillitis: These yellowish spots may coalesce => form a non-adherent yellowish true membrane
The tongue is furred and the breath is offensive.
Cervical signs: Enlarged tender jugulo-digastric lymph nodes (just below the angle of the mandible).
Throat swab to confirm the diagnosis
DIFFERENTIAL DIAGNOSIS:
1- Simple acute pharyngitis.2- Infectious Mononucleosis (glandular fever), Dx: blood test (monospot test).
ampicillin skin rash.
3- Scarlet fever. There is skin rash and strawberry tongue.
4- Diphtheria.
5- Ulcerative gingivitis.
6- Agranulocytosis.
Scarlet fever
الحمى القرمزيّةTreatment
Antibiotics therapy for 10 days to avoid recurrence.Penicillin is still the antibiotic of choice either orally, intramuscularly or intervenously.
Be aware of penicillin-resistance and give alternatives e.g.
Co-amoxiclave, Cephalosporin± Metronidasole.
Erythromycins were penicillin allergy
Supportive and symptomatic measures
bed rest
generous fluid intake
analgesics and antipyretics
gargles
Complications of tonsillitis:
Local complications:a) Pharyngeal suppurations --> peri-tonsillar abscess, para-pharyngeal abscess and retro-pharyngeal abscess.
b) Laryngitis
c) Otitis media
Systemic complications:
Rare and almost confined to childhood.
a) Rheumatic fever => carditis and arthritis.
b) Acute glomerulo-nephritis.
How? They are due to an auto-immune reaction i.e. the antibodies produced against Streptococcus beta-haemolyticus cross-react with the patient's own tissues
c) Septicaemia.
Chronic Tonsillitis
DEFINITION:
Chronic inflammation of the palatine tonsils.
AETIOLOGY:
It follows acute and subacute tonsillitis and is more common in children between the ages of 4-15 years. The predisposing factors are:
Organism factor: Repeated attacks of acute tonsillitis.
Treatment factor: inadequate dose or short course of antibiotics therapy.
Patient factor: Low patient's resistance e.g. malnutrition.
SYMPTOMS:
History of repeated attacks of acute tonsillitis.Sense of throat irritation => frequent hawking and hemming to clear the throat.
Bad mouth odour ( halitosis ) => due to accumulation of pus in the crypts
Difficult swallowing; if hypertrophic.
Snoring and obstructive sleep apnea --> if hypertrophic.
SIGNS:
Persistent enlargement of the jugulo-digastric lymph nodes
Marked tonsillar enlargement with congested anterior pillars.
Squeezing: The crypts ooze pus on pressure by a tongue depressor
TREATMENT:
Tonsillectomy operation; when chronic tonsillitis is symptomatic
Peri-tonsillar Abscess (Quinsy)
DefWhat is peri-tonsillar space?
Side
Site
Etiology
Collection of pus in the peri-tonsillar space
• is a connective tissue space which lies
• between the tonsil capsule and its
• Bed ( superior constrictor muscle)
• Acute tonsillitis
• The infection passes through CRYPTA
• MAGNA ( the largest tonsillar crypt)
Unilateral
Above & Lateral to the tonsilSymptoms
General: The patient looks ill with fever / rigor.
Pharyngeal:
The sore throat becomes severe throbbing pain radiating to the ear
The difficult swallowing becomes severe dysphagia to the limit that the patient can not swallow his own saliva
In a patient having
Acute Tonsillitis
The symptoms become
more severe
Signs
General :high feverPharyngeal:
The soft palate above the tonsil is hyperaemic & swollen
On pus formation it pits on blunt probing
The uvula is edematous and pushed medially
The tonsil is pushed downwards and medially
Ttrismus due to reflex muscle spasm
Cervical
Enlarged tender cervical LNuvula
TreatmentMedical: with massive antibiotic therapy
Surgical:
- Drainage of the abscess
- Tonsillectomy : after 4-6 weeks Why? To avoid recurrence
In the stage of peri-tonsillitis
• After pus formation
Technique of incision & Drainage of Quinsy
TonsillectomyIndications
• Recurrent attacks of acute tonsillitis
• That interfere with the patient's general health (5-6/yr. for at least 2 years).
• Peritonsillar abscess (quinsy).
• Sleep apnea syndrome
• Tonsillectomy for biopsy purposes when the tonsils are thought to be the site of neoplasm.
• Diphtheria carriers.
• Recurrent attacks of otitis media.
• Acute rheumatic fever and acute nephritis if streptococcus tonsillitis has been responsible for recurrence.
Contraindications
Bleeding disorders.Acutely inflamed tonsils and recent upper respiratory tract infection.
Epidemic of poliomyelitis: There is evidence that the virus may gain access to the exposed nerve sheaths and so give rise to the more fatal bulbar form of the disease.
Cleft palate because tonsillectomy leads to scarring of soft palate which affects repair and speech.
Complication of tosillectomy
Hemorrhage is the most common complication (2 – 3 % of operations).Primary haemorrhage (within the first 24 hours) is often treated surgically.
Secondary haemorrhage (after 24 hours of surgery) is believed to be due to sepsis. Conservative management with antibiotics often works.
Pain including otalgia
Dehydration
Weight loss Common in children who do not eat
Post-operating airway obstruction (because uvular odema and hematomas)
Voice changes
Plummer Vinson's Syndrome
Paterson Brown-Kelly SyndromeA chronic atrophic type of inflammation of the mucous membrane of the mouth, pharynx and upper end of esophagus presents as a classical triad of dysphagia, iron-deficiency anemia and esophageal webs
• Age: Middle age
• Sex: 90% in females
• Aetiology: Un-clear, may be
• iron deficiency anemia
• Vitamin deficiency
• or autoimmune processes
• Pathology: Atrophy of :
• Pharyngeal
• Esophageal &
• Gastric mucosa
Symptoms
General
PharyngealWeakness, fatigue, and dyspnea
are Secondary to iron deficiency
anemia
• Signs
• General
• Pharyngeal
• Dysphagia, if present, is typically
• intermittent and limited to solids.
• It is usually felt in the throat
• Angular stomatitis
• Glossitis
• Atrophic glazed mucosa of the
• hypopharynx
• Koilonychia
• Spleenomegaly
• Pallor
Investigations
ComplicationsTreatment
- Stricture at the cricopharyngeal
Sphincter- Pre-cancerous: postcricoid
carcinoma &esophageal carcinoma
• Blood picture: hypochromic anemia
• Gastric secretion: achlorohydria due to atrophy of gastric mucosa
• Barium swarllow
• Hypopharyngoscopy
• Iron & vitamine supply
• Repeated endoscopic dilatation
• Regular follow up for early detection of
• postcricoid carcinoma &esophageal
• carcinoma
Web
Globus Pharyngeus (Globus Hystericus)
Definition: Sensation of lump in the throat affecting mainly middle aged females, which is brought on or made worse by anxiety.Aetiology
The condition is often regarded as functional in which no organic cause can be found.
Recently the most accepted organic theory is gastroesophageal reflux diseases (GERD).
Clinical picture
Intermittent sensation of lump in the throat usually felt at or above the sternal notch, noticed when the patient is swallowing saliva and relieved by meals!There is no true dysphagia and no weight loss and the patient often has psychological stress or cancer phobia.
Treatment:
Reassurance that there is no organic disease or cancerAntireflux therapy: Omeprazole +Domperidone
Psychiatric consultation is required in selected cases
Remember that: dysphagia + weight loss + pain radiating to the ear + enlarged neck lymph node= Malignancy is the cause until proven otherwise!!!
شكرا